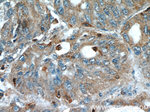
COTL1 Antibody in Immunohistochemistry (Paraffin) (IHC (P))

Search
Proteintech
COTL1 Monoclonal Antibody (4A3D9)
{{$productOrderCtrl.translations['antibody.pdp.commerceCard.promotion.promotions']}}
{{$productOrderCtrl.translations['antibody.pdp.commerceCard.promotion.viewpromo']}}
{{$productOrderCtrl.translations['antibody.pdp.commerceCard.promotion.promocode']}}: {{promo.promoCode}} {{promo.promoTitle}} {{promo.promoDescription}}. {{$productOrderCtrl.translations['antibody.pdp.commerceCard.promotion.learnmore']}}
产品信息
60237-1-IG
种属反应
宿主/亚型
分类
类型
克隆号
抗原
偶联物
形式
浓度
规格
纯化类型
保存液
内含物
保存条件
运输条件
产品详细信息
Immunogen sequence: MATKIDKEA CRAAYNLVRD DGSAVIWVTF KYDGSTIVPG EQGAEYQHFI QQCTDDVRLF AFVRFTTGDA MSKRSKFALI TWIGENVSGL QRAKTGTDKT LVKEVVQNFA KEFVISDRKE LEEDFIKSEL KKAGGANYDA QTE (1-142 aa encoded by BC010884)
靶标信息
This gene encodes one of the numerous actin-binding proteins which regulate the actin cytoskeleton. This protein binds F-actin, and also interacts with 5-lipoxygenase, which is the first committed enzyme in leukotriene biosynthesis. Although this gene has been reported to map to chromosome 17 in the Smith-Magenis syndrome region, the best alignments for this gene are to chromosome 16. The Smith-Magenis syndrome region is the site of two related pseudogenes.
仅用于科研。不用于诊断过程。未经明确授权不得转售。
篇参考文献 (0)
生物信息学
蛋白别名: coactosin-like 1; Coactosin-like protein; deduced protein product shows significant homology to coactosin from Dictyostelium discoideum; epididymis secretory sperm binding protein; FLJ43657; MGC19733; unnamed protein product
基因别名: 1810074P22Rik; 2010004C08Rik; CLP; COTL1
UniProt ID: (Human) Q14019, (Mouse) Q9CQI6
Entrez Gene ID: (Human) 23406, (Mouse) 72042